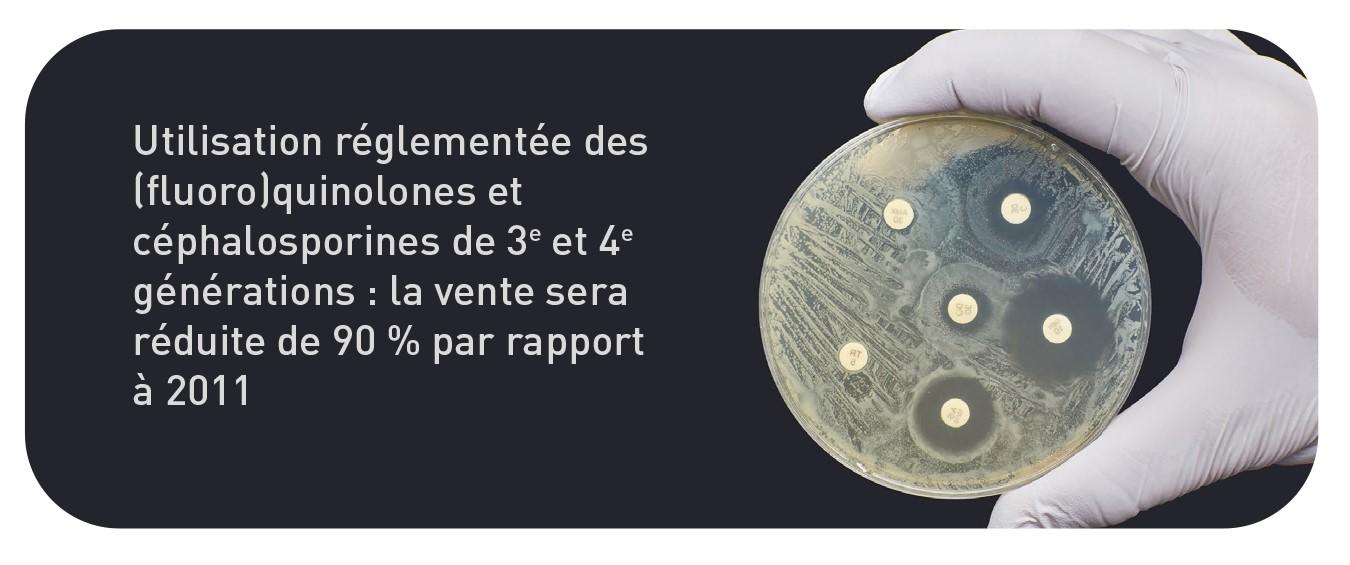

Cinq objectifs

Neuf points d'action
Pour atteindre ces objectifs, neuf points d'action ont également été prévus dans la vision AMCRA 2030.
Centre de connaissances concernant l'utilisation des antibiotiques
et l'antibiorésistance chez les animaux
Pour atteindre ces objectifs, neuf points d'action ont également été prévus dans la vision AMCRA 2030.